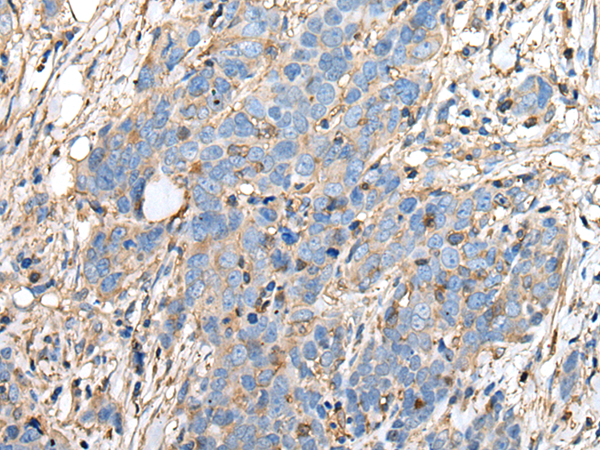

中文名稱: 兔抗PLAAT3多克隆抗體
英文名稱: Anti-PLAAT3 rabbit polyclonal antibody
別 名: phospholipase A and acyltransferase 3; AdPLA; HRSL
相關(guān)類別: 一抗
儲 存: 冷凍(-20℃)
宿 主: Rabbit
抗 原: PLAAT3
反應(yīng)種屬: Human, Mouse, Rat
標(biāo) 記 物: Unconjugate
克隆類型: rabbit polyclonal
技術(shù)規(guī)格
|
IHC Recommend dilution: |
30-150 |
|
IHC positive control: |
Human thyroid cancer and Human tonsil |
|
SwissProt: |
P53816 |
|
Synonyms: |
AdPLA; HRSL3; HRASLS3; HREV107; PLA2G16; PLAAT-3; H-REV107; HREV107-1; HREV107-3; H-REV107-1 |
|
Full name: |
phospholipase A and acyltransferase 3 |
|
Immunogen: |
Synthetic peptide of human PLAAT3 |
|
Name of antibody: |
PLAAT3 |
|
Applications: |
ELISA, IHC |
|
Background: |
Exhibits both phospholipase A1/2 and acyltransferase activities (PubMed:19615464, PubMed:19047760, PubMed:22825852, PubMed:22605381, PubMed:26503625). Shows phospholipase A1 (PLA1) and A2 (PLA2) activity, catalyzing the calcium-independent release of fatty acids from the sn-1 or sn-2 position of glycerophospholipids (PubMed:19615464, PubMed:19047760, PubMed:22825852, PubMed:22605381, PubMed:22923616). For most substrates, PLA1 activity is much higher than PLA2 activity (PubMed:19615464). Shows O-acyltransferase activity,catalyzing the transfer of a fatty acyl group from glycerophospholipid to the hydroxyl group of lysophospholipid (PubMed:19615464). Shows N-acyltransferase activity, catalyzing the calcium-independent transfer of a fatty acyl group at the sn-1 position of phosphatidylcholine (PC) and other glycerophospholipids to the primary amine of phosphatidylethanolamine (PE), forming N-acylphosphatidylethanolamine (NAPE), which serves as precursor for N-acylethanolamines (NAEs) (PubMed:19615464, PubMed:19047760, PubMed:22825852, PubMed:22605381). Exhibits high N-acyltransferase activity and low phospholipase A1/2 activity (PubMed:22825852). |

購物車
幫助
021-54845833/15800441009
